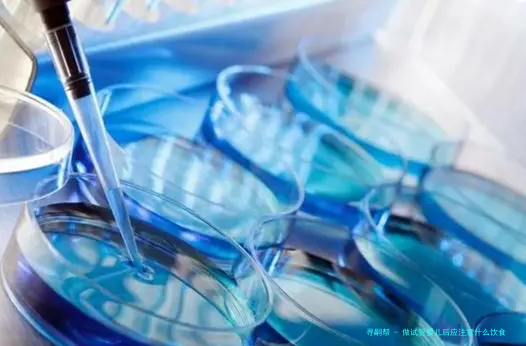

试管婴儿(试管婴儿(IVF))是通过采促排卵子和精子在实践室技术帮助下,将卵子和精子结合在一起完毕受精繁育受精胚胎并管移植到宫腔的技术。试管婴儿后,众多食物可能会对接受试管婴儿治疗的主妇发生不良影响。
因此做试管婴儿后应该注意饮食,合理安排伙食,为了避免止外源性污染,推动受精的顺利进展。
1、饮食应以新鲜的蔬菜、瓜果、高蛋白质食物和少量油质为主,以促进自己身体内的新陈代谢,帮助受精和胚胎繁殖。
二、预防吃油脂含量高、加工食物和零食,尽可能降低茶、咖啡、可乐等含咖啡因饮品的食入,以防止过度摄取咖啡因,影响排卵及植入胚胎。
3、可以吃一些含有较多蛋白质的食品,如牛乳、豆腐、海鱼、虾类、精肉等,对胚胎发育有很好的帮助。
四、要保证足够的热量摄入,增加高维生素、高纤维素食品的摄入,增强肌体的能量,为了便于领受较好的环境。
⑸调理膳食比例,碳水化合物化学化合物占比例不宜少于50%,蛋白质的比率掌握在百分之十五~30%,脂肪掌握在25%~35%,同时尽可能减少水分摄入。
领受试管婴儿治疗的妇女在饮食安排上必要要健康、养分,根据自我实际情况检查筛选化,坚持每天摄入蔬菜、瓜果、碳水化合物和包含较多
做完试管婴儿后应该注意饮食,不只是为了推动痊愈,仍旧有显著的影响治疗成果。因此妈宝在复元期间选择愈发健康的饮食及饮食风俗的改观必不可少。
1、增加摄取营养物质:妈宝应在天天饮食中摄取足够营养物质,如蛋白质,维生素,矿物资,微量要素等,以支持机体的推陈出新和生理活动;
⑵平淡养生:妈宝应注意每日饮食清淡,预防吃辛辣刺激性食物,以免刺激胃内,影响消化和影响消化和养分摄取;
3、多吃新鲜蔬果:清爽蔬果有许多营养物质对肌体有益,可以改善营养,有助于提高肌体的免疫性;
4、适度添补水分:妈宝在日常饮食中要多适当增补水分,保持充沛充沛的水份,省得出现体质脱水局面;
5、少量多餐:宝妈应当留意小部分多餐食用,特别在复元阶段更要在乎莫要多吃多嚼,以免过多摄入,对痊愈有影响。
Tips:
妈宝在复元期间应当留意选择越发健康的饮食及饮食习惯,多吃新鲜蔬果,多摄取营养物质,清淡养生,适度补充水份,少量多餐,省得影响试管婴儿的治疗成果。
